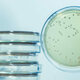
Microbiologia 2 e1556317680514

-
 de lenta acumulación de observaciones (desde 1675 aproximadamente hasta la mitad del siglo XIX), que arranca con el descubrimiento de los microorganismos por Leeuwenhoek (1675)
de lenta acumulación de observaciones (desde 1675 aproximadamente hasta la mitad del siglo XIX), que arranca con el descubrimiento de los microorganismos por Leeuwenhoek (1675) -
de cultivo de microorganismos, que llega hasta finales del siglo XIX, donde las figuras de Pasteur y Koch encabezan el logro de cristalizar a la microbiología como ciencia experimental bien asentada.
-
Luis Pasteur (1822- 1895) demostró que los mohos y las bacterias no se generan de forma espontánea y que no llegan a proliferar en un medio estéril, es así que dentro de los logros más destacados se encuentra el desarrollo de la técnica de calentamiento controlado que actualmente se conoce como la pasteurización, procedimiento que es utilizado por empresas alimenticias en la preservación de bebidas y sustancias alimenticias; mientras que en el ámbito de la medicina y la microbiología .
-
Sostuvo que las infecciones postoperatorias eran causadas por microorganismos, los cuales al ingresar por la herida causaban la putrefacción y la sepsis de la misma, por lo que ésta teoría lo llevó a tomar medidas de seguridad, como rociar fenol en sus pacientes antes de una intervención quirúrgica.
-
 btuvo el biológico liofilizado antivariólico, en ese mismo año realizó estudios en el oriente boliviano en la región de San Joaquín, Beni, acerca de la fiebre hemorrágica boliviana, ya en 1963 junto a un grupo de investigadores de la Middle American Research Unite, logró encontrar al principal portador del virus del machupo.
btuvo el biológico liofilizado antivariólico, en ese mismo año realizó estudios en el oriente boliviano en la región de San Joaquín, Beni, acerca de la fiebre hemorrágica boliviana, ya en 1963 junto a un grupo de investigadores de la Middle American Research Unite, logró encontrar al principal portador del virus del machupo.